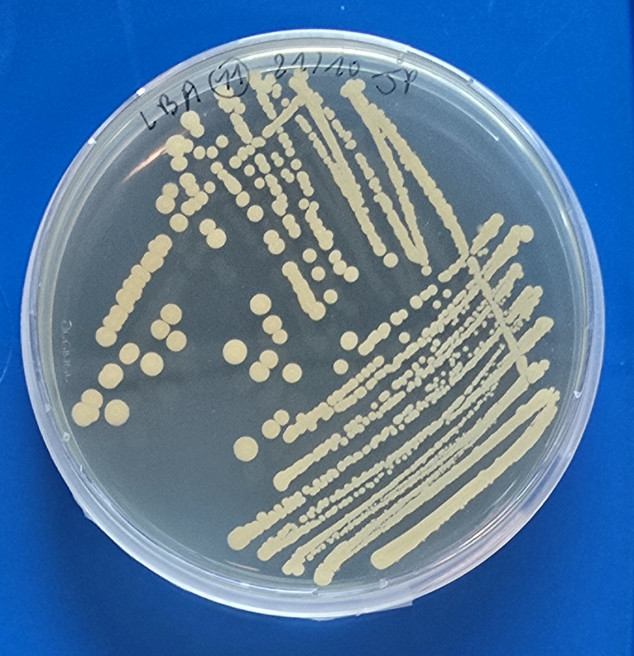
Seed endophyte

Harnessing the seed microbiome for seed and plant performance under stress - MiSeed internship (vacature in het Engels)
Harnessing the seed microbiome for seed and plant performance under stress - MiSeed internship (vacature in het Engels)
Microbiële EcologieContact Person:
Droevendaalsesteeg 10
6708 PB Wageningen
Project Description
The seed microbiome has gained increasing interest since it influences key aspects of plant life, including germination, seedling vigour, nutrient uptake, and tolerance to biotic and abiotic stresses. However, the microbial functions and molecular mechanisms that link seed-associated microbes to seed and plant performance remain largely unknown.
Would you like to contribute to novel research in plant-microbe interactions? We are looking for a motivated student to join the ‘MiSeed’ project which aims to elucidate whether the seed microbiome shapes seed performance and plant resilience to drought and pathogens, and how.
This project is part of MiSeed, funded by NWO, Enza Zaden, and Barenbrug, in collaboration with WUR (Wageningen University & Research), Wageningen.
Main activities
- Contribute to the isolation and characterization of the seed endophytic microbiome.
- Investigate how seed-associated microbes (e.g., via inoculation or VOCs) influence seed germination and early seedling growth under drought and/or pathogen pressure.
- Take part in group meetings (e.g., give research updates, communicate results and contribute to the discussions).
Approaches & techniques
Bioassays, isolating and culturing techniques, DNA extraction, PCR.
What we are looking for
- Background in microbiology, plant science, and/or ecology.
- Interest and motivation for laboratory research, data analysis and interpretation.
- English proficiency.
Details
- MSc/BSc students
- Duration: 3-6 months
- Starting date: open from January 2026
- Supervision team: MSc Joséphine Pottier (PhD student, NIOO), Prof. Paolina Garbeva (NIOO), Asst Prof. Rumyana Karlova (WUR)
- Location: Netherlands Institute of Ecology (NIOO), Wageningen
Contact & application
Joséphine Pottier j.pottier@nioo.knaw.nl
Relevant literature
Bergna, A., Cernava, T., Rändler, M., Grosch, R., Zachow, C., & Berg, G. (2018). Tomato Seeds Preferably Transmit Plant Beneficial Endophytes. Phytobiomes Journal, 2(4), 183–193.
Garrido-Sanz, D., & Keel, C. (2025). Seed-borne bacteria drive wheat rhizosphere microbiome assembly via niche partitioning and facilitation. Nature Microbiology, 1–15.
Hone, H., Mann, R., Yang, G., Kaur, J., Tannenbaum, I., Li, T., Spangenberg, G., & Sawbridge, T. (2021). Profiling, isolation and characterisation of beneficial microbes from the seed microbiomes of drought tolerant wheat. Scientific Reports, 11(1), 11916.
Matsumoto, H., Fan, X., Wang, Y., Kusstatscher, P., Duan, J., Wu, S., Chen, S., Qiao, K., Wang, Y., Ma, B., Zhu, G., Hashidoko, Y., Berg, G., Cernava, T., & Wang, M. (2021). Bacterial seed endophyte shapes disease resistance in rice. Nature Plants, 7(1), 60–72.